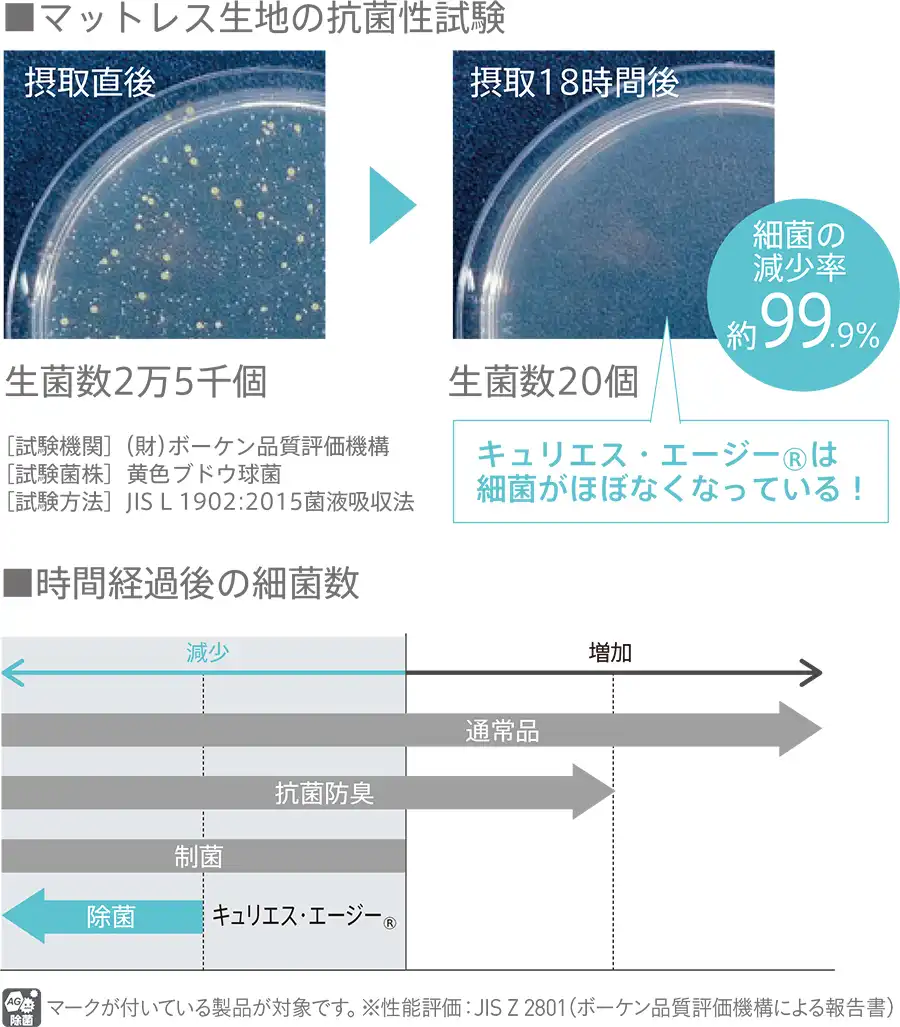

柔らかいか・硬いか、そのどちらかでマットレスを選んでいませんか?
最良のバランスが「わたしを解放する」。
LIFE TREATMENTは、人生に潤いを与えるマットレス。
4タイプ×ハードorソフトから最適なマットレスを選べます。

1快適な眠りには、理由がある

寝心地と寝姿勢
良い寝姿勢とは、「立っているときに近い自然な姿勢を保ち、体への負担が少ない状態のこと」とされています。
柔らかすぎると体が沈み込み寝返りしづらく、硬すぎると体圧による血流の妨げになります。
体を受け止める表層はやさしいフィット感、体や腰などを支えるスプリングは高い支持力、この2つのバランスが、質の高い眠りへ導きます。
23つの構成バランスで最良の寝心地と寝姿勢

スプリング、詰め物、付加価値、それら全てが三位一体となってマットレスの価値が決まります
3高密度連続スプリング®
フランスベッドが長年の研究で導き出したスプリングの答え、それが「高密度連続スプリング®」。精巧に編みあげた一本の鋼線が可能にした、つぎ目のない一体化した中空構造は、面全体で荷重を分散するため部分的な落ち込みがなく、安定した寝姿勢を保ちます。
寝た時の背筋が伸びる感覚、寝返りのしやすさ、高い通気性・耐久性など、日本人の骨格、日本の気候に適した構造が唯一の寝心地へと導きます。

快眠の大切な条件、「自然な寝返り」がしやすい
健康な睡眠を維持するために不可欠な動作として、人は睡眠時に約20回の寝返りをうつと言われています。
高密度連続スプリング®はカラダの重い部分を広い面積でしっかりと支えるため、余計な力を使わずに自然な寝返りができるのです。
高い耐久性と品質
鋼線を編み上げた高密度連続スプリング®は荷重の分散性が高い構造のためヘタリにくく、さらに高通気のため素材が痛みにくく製品のロングライフを実現しています。
また、フランスベッドでは日本の国家規格であるJIS規格よりも厳格な「FES規格」を制定し、徹底した品質管理を実施。
高密度連続スプリング®マットレスは様々な検査基準をクリアした安心の「フランスベッド品質」です。
風透るスプリング
「高密度連続スプリング®」は継ぎ目のない一体化した中空構造により、高温多湿な日本の環境に適した高い通気性を実現。
内部に空気をこもらせず換気しやすい構造で、すばやく湿気を放出させるため衛生的です。




4より快適に使える独自機能

プロ・ウォール®
マットレスの端をフランスベッド独自の技術「コールドキュアフォーム」一体成型で強化。
端が沈み込まず、どこへ寝返りしても変わらない安定感はマットレスの有効面積をぐっと広げ、ゆったりとした開放感を約束します。
また、マットレス2台を並べた際の「つぎ目」さえ感じさせないフラットな使い心地が、睡眠の質向上へつながります。


5生地に除菌機能糸を使用

キュリエス・エージー®
銀イオンの力で菌を減少させる「除菌機能糸」を採用。
抗菌を上回る性能で、目に見えない安心と健やかな眠りをかなえます。さらに繊維自体に加工が施されているため、
機能耐久性に優れています。
悪臭などの原因となるさまざまな細菌への効果が実証されています。
※当社のマットレスは、全て抗菌・防臭・防ダニ機能が標準設定されています。
6リサイクルまで考えたマットレス




環境配慮型マットレス
モアリー®の2分割スプリングを分割なしにした「モアリー®N」。
フランスベッドでは今後プロ・ウォール®仕様マットレスを「モアリー®N」にしていくことで、この環境配慮型マットレスの市場普及率を高め、持続可能な社会の実現を目指してまいります。
7シリーズ一覧
LT Lex1
寝心地性能や品質のバランスに優れたエントリーモデル

[スプリング]
高密度連続スプリング®
[詰物]
海洋プラスチック対策再生ポリエステル綿
羊毛綿
ウレタンフォーム
[生地]
ダブルニット生地(除菌機能糸使用)
ジャンプキルト
[仕様]
プロ・ウォール®仕様
モアリー®N仕様
[機能]
防ダニ・抗菌防臭加工
除菌効果(キュリエス・エージー®)
※両面仕様
※SS・ワイドダブルサイズ・クイーン・全てのサイズのロングタイプは受注生産(納期:28日)
- セミシングル
- 幅850×長さ1950/ロング2050×高さ260mm ¥198,000~
- シングル
- 幅970×長さ1950/ロング2050×高さ260mm ¥198,000~
- セミダブル
- 幅1220×長さ1950/ロング2050×高さ260mm ¥220,000~
- ダブル
- 幅1400×長さ1950/ロング2050×高さ260mm ¥242,000~
- ワイドダブル
- 幅1540×長さ1950/ロング2050×高さ260mm ¥264,000~
- クイーン
- 幅1710×長さ1950/ロング2050×高さ260mm ¥396,000~
LT Lex2
高触感フォームを採用しフィット感のあるしなやかな寝心地

[スプリング]
高密度連続スプリング®
[詰物]
海洋プラスチック対策再生ポリエステル綿
羊毛綿
高触感ウレタンフォーム
[生地]
ダブルニット生地(除菌機能糸使用)
ジャンプキルト
[仕様]
プロ・ウォール®仕様
モアリー®N仕様
[機能]
防ダニ・抗菌防臭加工
除菌効果(キュリエス・エージー®)
※両面仕様
※SS・ワイドダブルサイズ・クイーン・全てのサイズのロングタイプは受注生産(納期:28日)
- セミシングル
- 幅850×長さ1950/ロング2050×高さ280mm ¥242,000~
- シングル
- 幅970×長さ1950/ロング2050×高さ280mm ¥242,000~
- セミダブル
- 幅1220×長さ1950/ロング2050×高さ280mm ¥264,000~
- ダブル
- 幅1400×長さ1950/ロング2050×高さ280mm ¥286,000~
- ワイドダブル
- 幅1540×長さ1950/ロング2050×高さ280mm ¥308,000~
- クイーン
- 幅1710×長さ1950/ロング2050×高さ280mm ¥484,000~
LT Lex3
高触感フォームと100%天然ラテックスフォームを採用
ほどけるような肌あたりと上質な寝心地を実現

[スプリング]
高密度連続スプリング®
[詰物]
海洋プラスチック対策再生ポリエステル綿
羊毛綿
高触感ウレタンフォーム
100%天然ラテックスフォーム
[生地]
ダブルニット生地(除菌機能糸使用)
ジャンプキルト
[仕様]
プロ・ウォール®仕様
モアリー®N仕様
[機能]
防ダニ・抗菌防臭加工
除菌効果(キュリエス・エージー®)
※両面仕様
※SS・ワイドダブルサイズ・クイーン・全てのサイズのロングタイプは受注生産(納期:28日)
- セミシングル
- 幅850×長さ1950/ロング2050×高さ300mm ¥286,000~
- シングル
- 幅970×長さ1950/ロング2050×高さ300mm ¥286,000~
- セミダブル
- 幅1220×長さ1950/ロング2050×高さ300mm ¥319,000~
- ダブル
- 幅1400×長さ1950/ロング2050×高さ300mm ¥352,000~
- ワイドダブル
- 幅1540×長さ1950/ロング2050×高さ300mm ¥385,000~
- クイーン
- 幅1710×長さ1950/ロング2050×高さ300mm ¥572,000~
LT Lex4
高触感フォームと100%天然ラテックスフォームを採用
オーバートップ仕様がプレミアムな眠りへ誘います
LT-Lex シリーズの最上位モデル

[スプリング]
高密度連続スプリング®
[詰物]
海洋プラスチック対策再生ポリエステル綿
羊毛綿
高触感ウレタンフォーム
100%天然ラテックスフォーム
[生地]
ダブルニット生地(除菌機能糸使用)
ジャンプキルト
[仕様]
プロ・ウォール®仕様
モアリー®N仕様
オーバートップ仕様
[機能]
防ダニ・抗菌防臭加工
除菌効果(キュリエス・エージー®)
※両面仕様
※SS・ワイドダブルサイズ・クイーン・全てのサイズのロングタイプは受注生産(納期:28日)
- セミシングル
- 幅850×長さ1950/ロング2050×高さ320mm ¥330,000~
- シングル
- 幅970×長さ1950/ロング2050×高さ320mm ¥330,000~
- セミダブル
- 幅1220×長さ1950/ロング2050×高さ320mm ¥363,000~
- ダブル
- 幅1400×長さ1950/ロング2050×高さ320mm ¥396,000~
- ワイドダブル
- 幅1540×長さ1950/ロング2050×高さ320mm ¥429,000~
- クイーン
- 幅1710×長さ1950/ロング2050×高さ320mm ¥660,000~